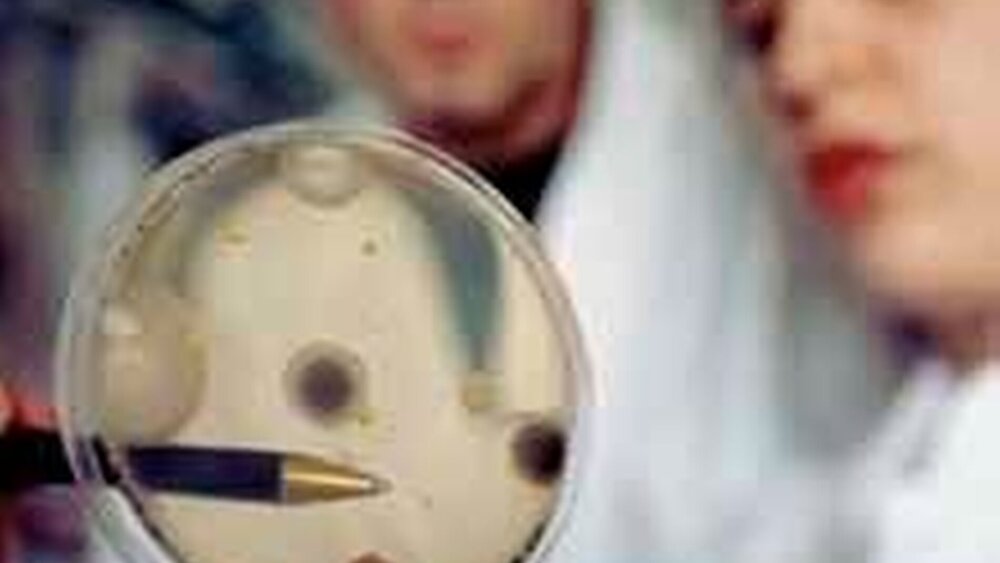

Wissenschaftliche Stellungnahmen und ihre Bedeutung für den Patienten
Beide Gesprächspartner machten deutlich, dass der Informationsbedarf des Patienten stetig wächst und er heute auf einem erheblich informierten Wissensstand ist. Diesen erhält er aus Broschüren, die bundesweit nicht nur von den Standes- und Wissenschaftsorganisationen herausgegeben werden, sondern auch von diversen privaten Fernsehsendern, bei denen die Gesundheitssendungen boomen, von der sogenannten Yellowpress sowie aus dem Internet. Hier gibt es eine Flut von Informationsmaterial mit zum Teil kontroversen Aussagen. „Denn der Patient kann nicht erkennen, welche Recherche oder evidenzbasierte Untersuchungen hinter den einzelnen Aussagen stecken“, bemerkte Dr. Oesterreich, und weiter: „... so ist der Wunsch, eine evidenzbasierte wissenschaftliche Aussage auch für den Patienten zu erstellen, um so größer.“
Patienteninformationen ...
Da der Zahnarzt in der Praxis gefordert ist, seinem Patienten die der Wissenschaft entsprechend möglichst beste Versorgung angedeien zu lassen, muss auch er sich ständig wissenschaftlich auf den neuesten Stand bringen. „Dass der Zahnarzt dieses tut, zeigt die immer größer werdende Beteiligung an Fortbildungsveranstaltungen, die der Zahnarzt oft mit Praxisausfall und hohen Nebenkosten auf rein freiwilliger Basis leistet“, so Laurisch. Denn er hat die Verantwortung für die dem Patienten angebotene und umgesetzte Therapie. Schon seit Jahren veröffentlicht die DGZMK wissenschaftliche Stellungnahmen zu aktuellen Therapieansätzen, die entsprechend der wissenschaftlichen Weiterentwicklung stetig aktualisiert werden.
Dr. Laurisch erklärt das Procedere: „Eine Stellungnahme wird von qualifizierten Fachleuten aus der entsprechenden Fachgesellschaft erarbeitet und redaktionell erstellt. Dann erhält der DGZMK-Vorstand dieses Papier, das dann wiederum durch alle Fachgesellschaften sowie assoziierte Fachgruppen gereicht wird. Jede berät für sich, ob es fachlicherseits noch etwaige Ergänzungen gibt. Letztendlich wird ein aktueller Abgleich im Vorstand verabschiedet, dann erst erfolgt eine Veröffentlichung in den Fachmedien (wie dgzmk.de, zm-online.de, dzz oder zm). Eine auf diese Weise erarbeitete Stellungnahme liefert also zuverlässige Fachinformation für den Zahnarzt und den Patienten, sollte er sie denn fachlich auch verstehen.
... wissenschaftlich unterlegt
Da dieses jedoch nicht immer der Fall sei, so Oesterreich, sei der Wunsch entstanden, eine demselben oben beschriebenen Weg vergleichbare Patienteninformation zu erstellen, für die dann beide Organisationen verantwortlich zeichnen. „Und diese Informationen sind nicht allein in dem sogenannten ‘Elfenbeinturm’ der Wissenschaftler entstanden, sondern auch der Umsetzbarkeit in der Praxis angeglichen“, ergänzte Laurisch. „Die neuen Patienteninformationen, die sich mit einem neuen, gemeinsamen Layout beider großen zahnärztlichen Organisationen neu präsentieren, zeigen eine gemeinsame Kompetenz und liefern daher einen hohen Standard an Qualitätssicherung. Nicht nur für den Patienten, sondern auch für den Zahnarzt“, so Oesterreich im Gespräch, „... und das alles nach der wissenschaftlich aktuellsten Datenlage.“ Das biete Therapiesicherheit für beide Seiten, für den Zahnarzt und den Patienten, fasste Markus Brakel zusammen.